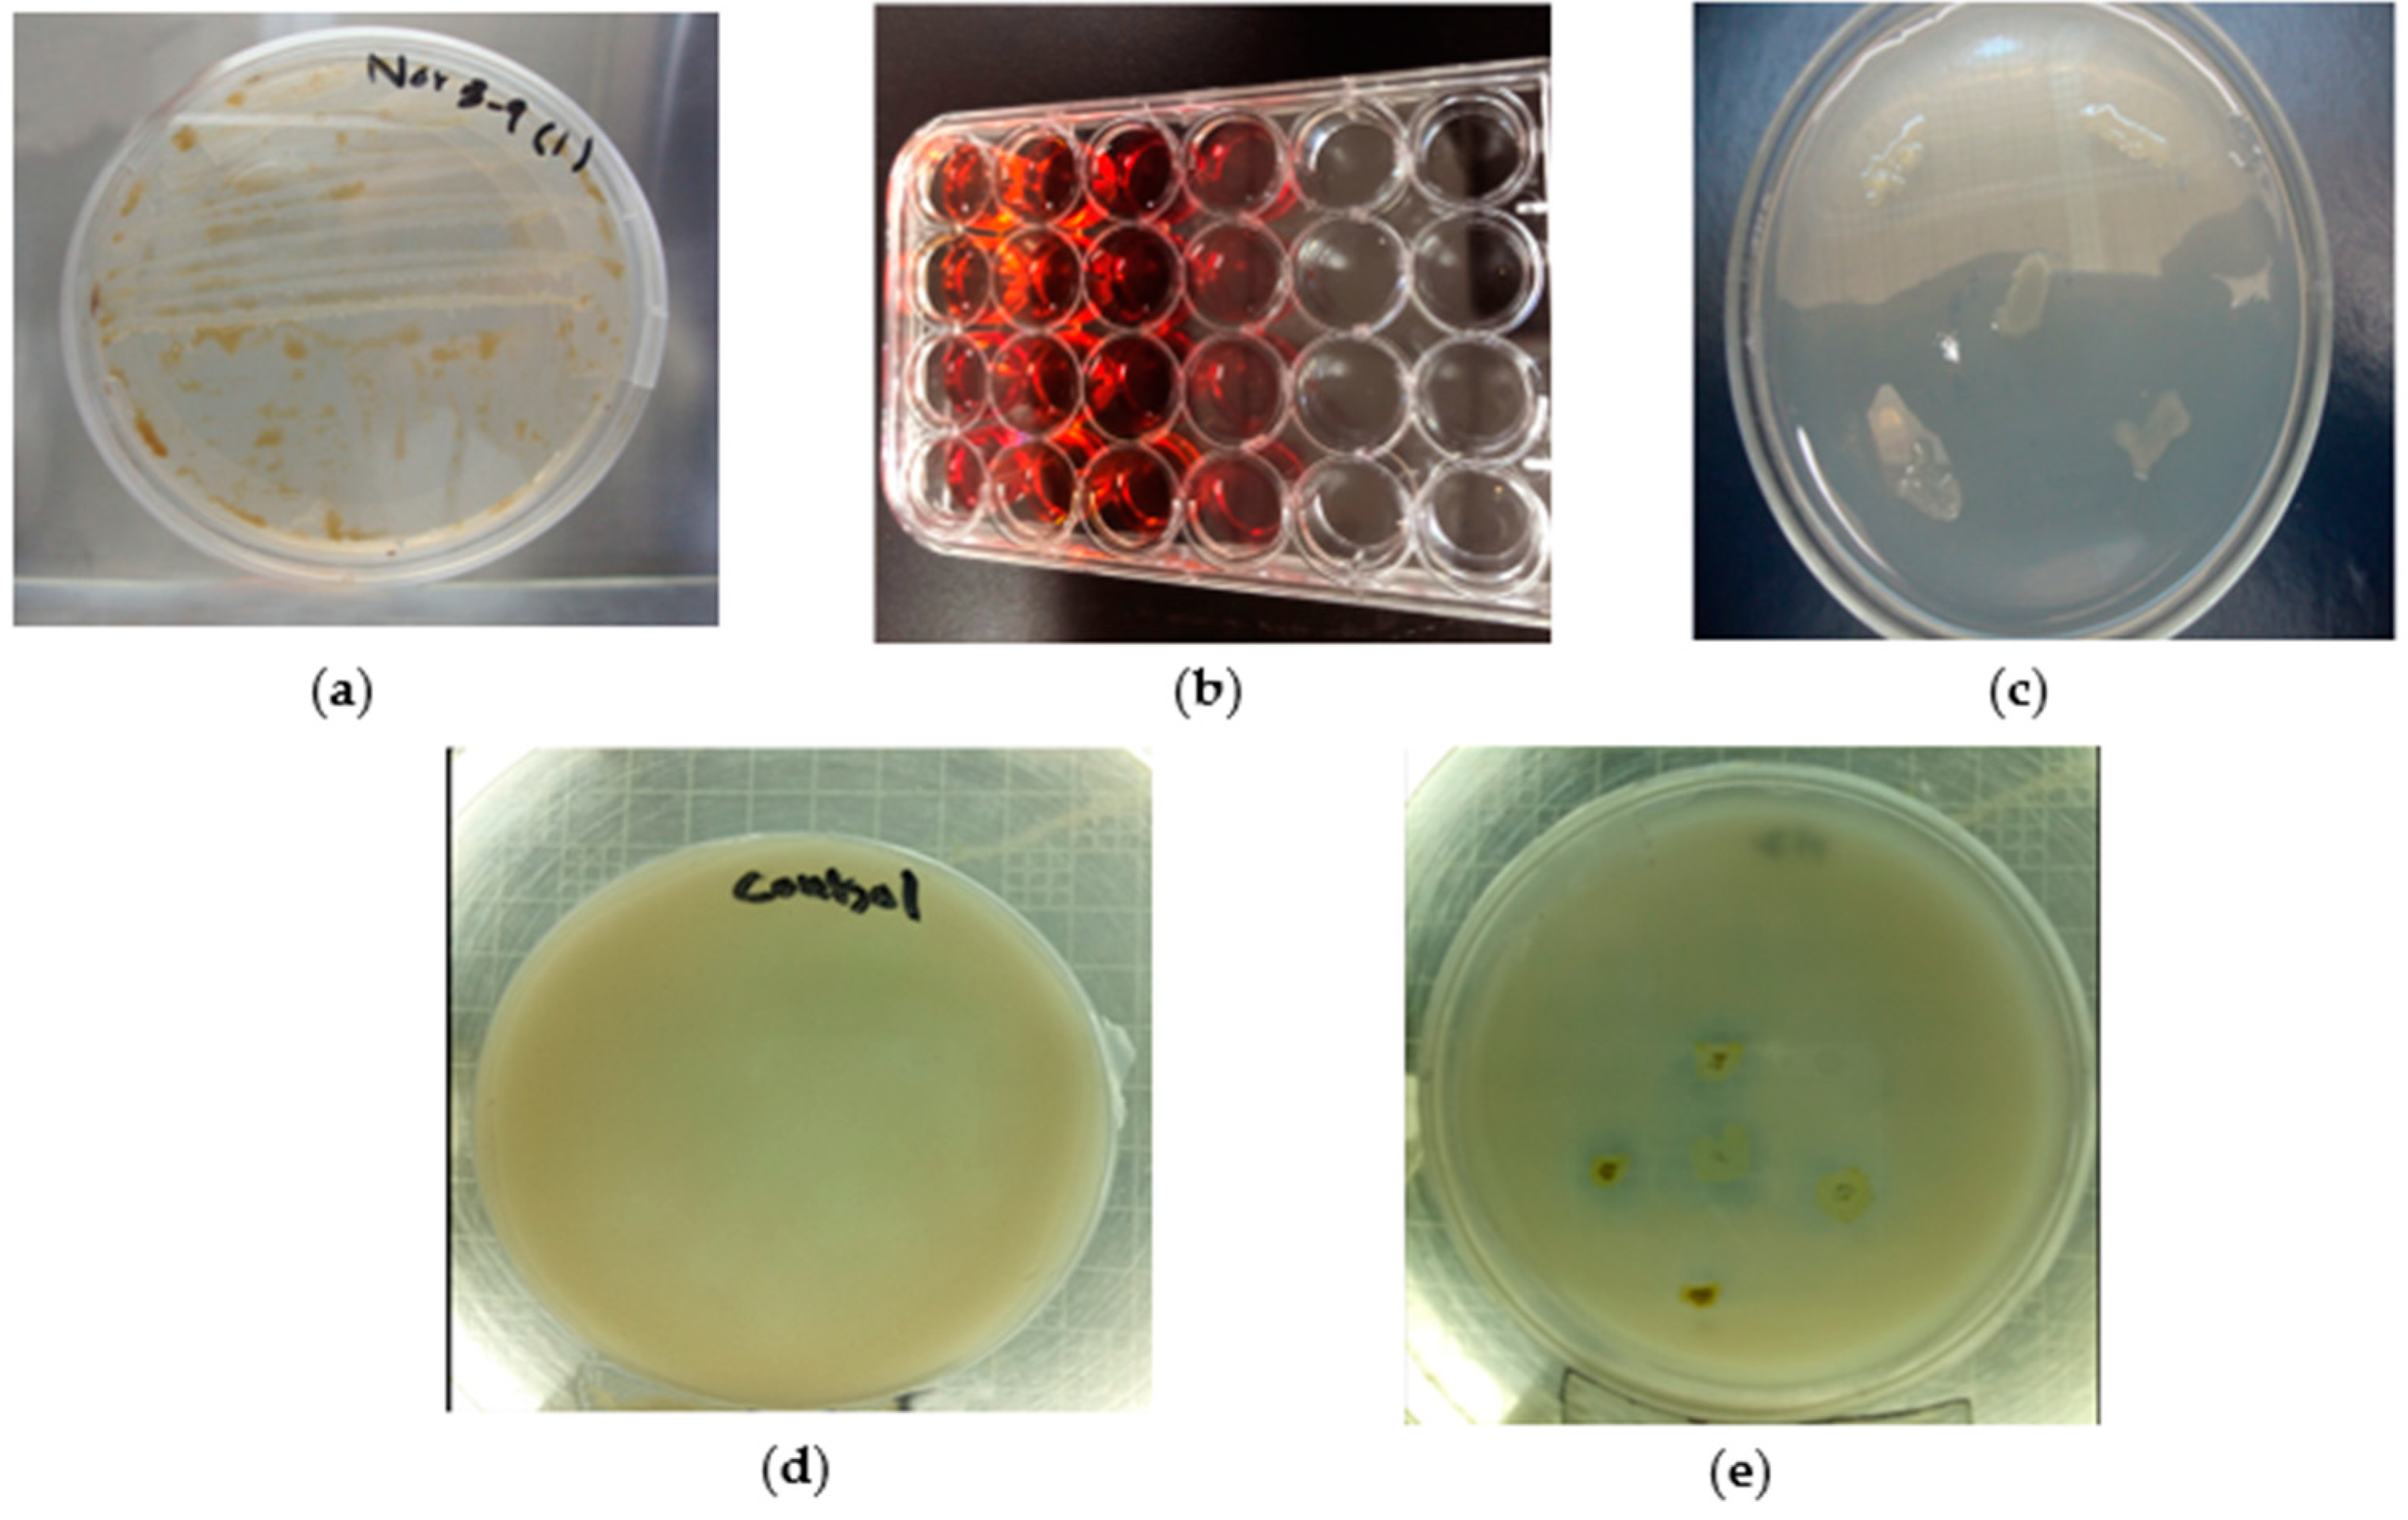
Applsci 11 03504 g002

Isolation and Characterization of Oil-Degrading Enterobacter sp. from Naturally Hydrocarbon-Contaminated Soils and Their Potential Use against the Bioremediation of Crude Oil
Abstract
1. Introduction
2. Materials and Methods
2.1. Reagents and Other Materials
2.2. Soil Sampling
2.3. Bacterial Isolation
2.4. Bioremediation Assay
2.5. Exoplysaccharide Production Assay
2.6. Phosphate Solubilization Assay
- Petriplates were prepared with the following media composition: (g/L) glucose—10 g: Ca3(PO4)2—5 g; MgCl2.6H2O—5 g; MgSO4.7H2O—0.25 g; KCl—0.2 g; and (NH4)2SO4—0.1 g.
- Each bacterial strain was represented by a loop on the plates (three per plate at different places).
- Plates were incubated for 2–3 days at 28 ± 1 °C [44].
2.7. Measurement of Total Petroleum Hydrocarbons by Infrared Spectroscopy
2.8. Experimental Setup and Observations
2.9. Bacterial 16S rRNA Sequencing
2.10. Statistical Analysis
3. Results
3.1. Bioremediation Assay, Exopolysaccharides, and Phosphate Solubilizing Ability
3.2. Growth Attributes of Maize
3.3. TPH Removal in Association with Maize
3.4. Bacterial Sequencing
3.5. Selection of TPH-Degrading and Growth-Promoting Strains
4. Discussion
5. Conclusions
Author Contributions
Funding
Institutional Review Board Statement
Informed Consent Statement
Acknowledgments
Conflicts of Interest
References
- Alam Cheema, S.; Khan, M.I.; Shen, C.; Tang, X.; Farooq, M.; Chen, L.; Zhang, C.; Chen, Y. Degradation of phenanthrene and pyrene in spiked soils by single and combined plants cultivation. J. Hazard. Mater. 2010, 177, 384–389. [Google Scholar] [CrossRef] [PubMed]
- Tang, W.-W.; Zeng, G.-M.; Gong, J.-L.; Liang, J.; Xu, P.; Zhang, C.; Huang, B.-B. Impact of humic/fulvic acid on the removal of heavy metals from aqueous solutions using nanomaterials: A review. Sci. Total Environ. 2014, 468–469, 1014–1027. [Google Scholar] [CrossRef] [PubMed]
- Bashir, M.A.; Naveed, M.; Ahmad, Z.; Gao, B.; Mustafa, A.; Núñez-Delgado, A. Combined application of biochar and sulfur regulated growth, physiological, antioxidant responses and Cr removal capacity of maize (Zea mays L.) in tannery polluted soils. J. Environ. Manag. 2020, 259, 110051. [Google Scholar] [CrossRef] [PubMed]
- Bashir, M.A.; Naveed, M.; Ashraf, S.; Mustafa, A.; Ali, Q.; Rafique, M.; Alamri, S.; Siddiqui, M.H. Performance of Zea mays L. cultivars in tannery polluted soils: Management of chromium phytotoxicity through the application of biochar and compost. Physiol. Plant. 2020. [Google Scholar] [CrossRef] [PubMed]
- Zeng, G.; Chen, M.; Zeng, Z. Risks of Neonicotinoid Pesticides. Science 2013, 340, 1403. [Google Scholar] [CrossRef] [PubMed]
- Takimoto, A.; Nair, P.K.R.; Alavalapati, J.R.R. Socioeconomic potential of carbon sequestration through agroforestry in the West African Sahel. Mitig. Adapt. Strat. Glob. Chang. 2008, 13, 745–761. [Google Scholar] [CrossRef]
- Nazli, F.; Mustafa, A.; Ahmad, M.; Hussain, A.; Jamil, M.; Wang, X.; Shakeel, Q.; Imtiaz, M.; El-Esawi, M. A Review on Practical Application and Potentials of Phytohormone-Producing Plant Growth-Promoting Rhizobacteria for Inducing Heavy Metal Tolerance in Crops. Sustainability 2020, 12, 9056. [Google Scholar] [CrossRef]
- Hu, G.; Li, J.; Zeng, G. Recent development in the treatment of oily sludge from petroleum industry: A review. J. Hazard. Mater. 2013, 261, 470–490. [Google Scholar] [CrossRef]
- Sabir, A.; Naveed, M.; Bashir, M.A.; Hussain, A.; Mustafa, A.; Zahir, Z.A.; Kamran, M.; Ditta, A.; Núñez-Delgado, A.; Saeed, Q.; et al. Cadmium mediated phytotoxic impacts in Brassica napus: Managing growth, physiological and oxidative disturbances through combined use of biochar and Enterobacter sp. MN17. J. Environ. Manag. 2020, 265, 110522. [Google Scholar] [CrossRef] [PubMed]
- Choi, S.-C.; Kae, K.K.; Jae, H.S.; Sang-Jin, K. Evaluation of fertilizer additions to stimulate oil biodegradation in sand seashore mesocosms. J. Microbiol. Biotechnol. 2002, 12, 431–436. [Google Scholar]
- Naveed, M.; Mustafa, A.; Azhar, S.Q.-T.-A.; Kamran, M.; Zahir, Z.A.; Núñez-Delgado, A. BurkholderiaphytofirmansPsJN and tree twigs derived biochar together retrieved Pb-induced growth, physiological and biochemical disturbances by mini-mizing its uptake and translocation in mung bean (Vignaradiata L.). J. Environ. Manag. 2020, 257, 109974. [Google Scholar] [CrossRef]
- Naveed, M.; Bukhari, S.S.; Mustafa, A.; Ditta, A.; Alamri, S.; El-Esawi, M.A.; Rafique, M.; Ashraf, S.; Siddiqui, M.H. Mitigation of Nickel Toxicity and Growth Promotion in Sesame through the Application of a Bacterial Endophyte and Zeolite in Nickel Contaminated Soil. Int. J. Environ. Res. Public Health 2020, 17, 8859. [Google Scholar] [CrossRef] [PubMed]
- Chen, M.; Xu, P.; Zeng, G.; Yang, C.; Huang, D.; Zhang, J. Bioremediation of soils contaminated with polycyclic aromatic hydrocarbons, petroleum, pesticides, chlorophenols and heavy metals by composting: Applications, microbes and future research needs. Biotechnol. Adv. 2015, 33, 745–755. [Google Scholar] [CrossRef]
- Xu, X.; Liu, W.; Tian, S.; Wang, W.; Qi, Q.; Jiang, P.; Gao, X.; Li, F.; Li, H.; Yu, H. Petroleum Hydrocarbon-Degrading Bacteria for the Remediation of Oil Pollution Under Aerobic Conditions: A Perspective Analysis. Front. Microbiol. 2018, 9, 2885. [Google Scholar] [CrossRef]
- Gargouri, B.; Karray, F.; Mhiri, N.; Aloui, F.; Sayadi, S. Bioremediation of petroleum hydrocarbons-contaminated soil by bacterial consortium isolated from an industrial wastewater treatment plant. J. Chem. Technol. Biotechnol. 2013, 89, 978–987. [Google Scholar] [CrossRef]
- Balba, M.; Al-Awadhi, N.; Al-Daher, R. Bioremediation of oil-contaminated soil: Microbiological methods for feasibility assessment and field evaluation. J. Microbiol. Methods 1998, 32, 155–164. [Google Scholar] [CrossRef]
- Huang, N.E.; Wu, Z. A review on Hilbert-Huang transform: Method and its applications to geophysical studies. Rev. Geophys. 2008, 46, 46. [Google Scholar] [CrossRef]
- Dias, R.L.; Ruberto, L.; Hernández, E.; Vázquez, S.C.; Balbo, A.L.; Del Panno, M.T.; Mac Cormack, W.P. Bioremediation of an aged diesel oil-contaminated Antarctic soil: Evaluation of the “on site” biostimulation strategy using different nutrient sources. Int. Biodeterior. Biodegrad. 2012, 75, 96–103. [Google Scholar] [CrossRef]
- Fuentes, S.; Méndez, V.; Aguila, P.; Seeger, M. Bioremediation of petroleum hydrocarbons: Catabolic genes, microbial communities, and applications. Appl. Microbiol. Biotechnol. 2014, 98, 4781–4794. [Google Scholar] [CrossRef] [PubMed]
- Graj, W.; Lisiecki, P.; Szulc, A.; Chrzanowski, Ł.; Wojtera-Kwiczor, J. Bioaugmentation with Petroleum-Degrading Consortia Has a Selective Growth-Promoting Impact on Crop Plants Germinated in Diesel Oil-Contaminated Soil. Water Air Soil Pollut. 2013, 224, 1–15. [Google Scholar] [CrossRef]
- Cheema, S.A.; Khan, M.I.; Tang, X.; Zhang, C.; Shen, C.; Malik, Z.; Ali, S.; Yang, J.; Shen, K.; Chen, X. Enhancement of phenanthrene and pyrene degradation in rhizosphere of tall fescue (Festuca arundinacea). J. Hazard. Mater. 2009, 166, 1226–1231. [Google Scholar] [CrossRef]
- Haider, F.U.; Liqun, C.; Coulter, J.A.; Alam Cheema, S.; Wu, J.; Zhang, R.; Wenjun, M.; Farooq, M. Cadmium toxicity in plants: Impacts and remediation strategies. Ecotoxicol. Environ. Saf. 2021, 211, 111887. [Google Scholar] [CrossRef] [PubMed]
- Younas, F.; Mustafa, A.; Farooqi, Z.U.R.; Wang, X.; Younas, S.; Mohy-Ud-Din, W.; Hameed, M.A.; Abrar, M.M.; Maitlo, A.A.; Noreen, S.; et al. Current and Emerging Adsorbent Technologies for Wastewater Treatment: Trends, Limitations, and Environmental Implications. Water 2021, 13, 215. [Google Scholar] [CrossRef]
- Piskonen, R.; Itävaara, M. Evaluation of chemical pretreatment of contaminated soil for improved PAH bioremediation. Appl. Microbiol. Biotechnol. 2004, 65, 627–634. [Google Scholar] [CrossRef] [PubMed]
- Radwan, S. Phytoremediation for oily desert soils. In Advances in Applied Bioremediation; Springer: Berlin/Heidelberg, Germany, 2009; pp. 279–298. [Google Scholar]
- Szulc, A.; Ambrożewicz, D.; Sydow, M.; Ławniczak, Ł.; Piotrowska-Cyplik, A.; Marecik, R.; Chrzanowski, Ł. The influence of bioaugmentation and biosurfactant addition on bioremediation efficiency of diesel-oil contaminated soil: Feasibility during field studies. J. Environ. Manag. 2014, 132, 121–128. [Google Scholar] [CrossRef] [PubMed]
- Johnson, O.A.; Affam, A.C. Petroleum sludge treatment and disposal: A review. Environ. Eng. Res. 2018, 24, 191–201. [Google Scholar] [CrossRef]
- Siles, J.A.; Margesin, R. Insights into microbial communities mediating the bioremediation of hydrocarbon-contaminated soil from an Alpine former military site. Appl. Microbiol. Biotechnol. 2018, 102, 4409–4421. [Google Scholar] [CrossRef]
- Kreling, N.E.; Zaparoli, M.; Margarites, A.C.; Friedrich, M.T.; Thomé, A.; Colla, L.M. Extracellular biosurfactants from yeast and soil–biodiesel interactions during bioremediation. Int. J. Environ. Sci. Technol. 2019, 17, 395–408. [Google Scholar] [CrossRef]
- Huang, Y.; Zhou, H.; Zheng, G.; Li, Y.; Xie, Q.; You, S.; Zhang, C. Isolation and characterization of biosurfactant-producing Serratiamarcescens ZCF25 from oil sludge and application to bioremediation. Environ. Sci. Pollut. Res. 2020, 27, 27762–27772. [Google Scholar] [CrossRef]
- Li, X.; Li, Y. Preparation and modification of biomass carbon and research of the adsorption of copper. IOP Conf. Ser. Earth Environ. Sci. 2019, 300, 052034. [Google Scholar] [CrossRef]
- Varjani, S.J.; Gnansounou, E. Microbial dynamics in petroleum oilfields and their relationship with physiological properties of petroleum oil reservoirs. Bioresour. Technol. 2017, 245, 1258–1265. [Google Scholar] [CrossRef] [PubMed]
- Ma, Y.-L.; Lu, W.; Wan, L.-L.; Luo, N. Elucidation of fluoranthenedegradative characteristics in a newly isolated Achromobacterxylosoxidans DN002. Appl. Biochem. Biotechnol. 2015, 175, 1294–1305. [Google Scholar] [CrossRef]
- Mnif, S.; Sayadi, S.; Chamkha, M. Biodegradative potential and characterization of a novel aromatic-degrading bacterium isolated from a geothermal oil field under saline and thermophilic conditions. Int. Biodeterior. Biodegrad. 2014, 86, 258–264. [Google Scholar] [CrossRef]
- Abbasian, F.; Lockington, R.; Mallavarapu, M.; Naidu, R. A comprehensive review of aliphatic hydrocarbon biodegradation by bacteria. Appl. Biochem. Biotechnol. 2015, 176, 670–699. [Google Scholar] [CrossRef]
- Brown, D.M.; Okoro, S.; van Gils, J.; van Spanning, R.; Bonte, M.; Hutchings, T.; Linden, O.; Egbuche, U.; Bruun, K.B.; Smith, J.W. Comparison of landfarming amendments to improve bioremediation of petroleum hydrocarbons in Niger Delta soils. Sci. Total Environ. 2017, 596, 284–292. [Google Scholar] [CrossRef] [PubMed]
- Mukherjee, S.; Bardolui, N.K.; Karim, S.; Patnaik, V.V.; Nandy, R.K.; Bag, P.K. Isolation and characterization of a monoaromatic hydrocarbon-degrading bacterium, Pseudomonas aeruginosa from crude oil. J. Environ. Sci. Health A 2010, 45, 1048–1053. [Google Scholar] [CrossRef] [PubMed]
- Ali, M.H.; Sattar, M.T.; Khan, M.I.; Naveed, M.; Rafique, M.; Alamri, S.; Siddiqui, M.H. Enhanced Growth of Mungbean and Remediation of Petroleum Hydrocarbons by Enterobacter sp. MN17 and Biochar Addition in Diesel Contaminated Soil. Appl. Sci. 2020, 10, 8548. [Google Scholar] [CrossRef]
- Hesnawi, R.M.; Mogadami, F.S. Bioremediation of Libyan crude oil-contaminated soil under mesophilic and thermophilic conditions. APCBEE Procedia 2013, 5, 82–87. [Google Scholar] [CrossRef][Green Version]
- Jahromi, H.; Fazaelipoor, M.H.; Ayatollahi, S.; Niazi, A. Asphaltenes biodegradation under shaking and static conditions. Fuel 2014, 117, 230–235. [Google Scholar] [CrossRef]
- Bertani, G. Lysogeny at Mid-Twentieth Century: P1, P2, and Other Experimental Systems. J. Bacteriol. 2004, 186, 595–600. [Google Scholar] [CrossRef]
- Bushnell, L.D.; Haas, H.F. The Utilization of Certain Hydrocarbons by Microorganisms. J. Bacteriol. 1941, 41, 653–673. [Google Scholar] [CrossRef] [PubMed]
- Ashraf, M.; Hasnain, S.; Berge, O.; Mahmood, T. Inoculating wheat seedlings with exopolysaccharide-producing bacteria restricts sodium uptake and stimulates plant growth under salt stress. Biol. Fertil. Soils 2004, 40, 157–162. [Google Scholar] [CrossRef]
- Shabaan, M.; Asghar, H.N.; Akhtar, M.J.; Ali, Q.; Ejaz, M. Role of plant growth promoting rhizobacteria in the alleviation of lead toxicity to Pisumsativum L. Int. J. Phytoremediat. 2020, 1–9. [Google Scholar] [CrossRef] [PubMed]
- Yanagi, M.; Yamasato, K. Phylogenetic analysis of the family Rhizobiaceae and related bacteria by sequencing of 16S rRNA gene using PCR and DNA sequencer. FEMS Microbiol. Lett. 1993, 107, 115–120. [Google Scholar] [CrossRef] [PubMed]
- Tamura, M.N.; Fuse, S.; Azuma, H.; Hasebe, M. Biosystematic Studies on the Family Tofieldiaceae I. Phylogeny and Circumscription of the Family Inferred from DNA Sequences of matK and rbcL. Plant Biol. 2004, 6, 562–567. [Google Scholar] [CrossRef]
- Steel, R.G.D.; Torrie, J.H.; Dicky, D.A. Principles and Procedures of Statistics, A Biometrical Approach; McGraw Hill, Inc. Book Co.: New York, NY, USA, 1997; Volume 3. [Google Scholar]
- Baran, S.; Bielińska, E.J.; Wójcikowska-Kapusta, A. Enzymatic activity in the soils, contaminated with oil-derived products. Acta Agrophys. 2021, 2002, 9–19. [Google Scholar]
- Ghoreishi, G.; Alemzadeh, A.; Mojarrad, M.; Djavaheri, M. Bioremediation capability and characterization of bacteria isolated from petroleum contaminated soils in Iran. Sustain. Environ. Res. 2017, 27, 195–202. [Google Scholar] [CrossRef]
- Kvas, S.; Rahn, J.; Engel, K.; Neufeld, J.D.; Villeneuve, P.J.; Trevors, J.T.; Lee, H.; Scroggins, R.P.; Beaudette, L.A. Development of a microbial test suite and data integration method for assessing microbial health of contaminated soil. J. Microbiol. Methods 2017, 143, 66–77. [Google Scholar] [CrossRef]
- Gao, Y.; Zhu, L. Plant uptake, accumulation and translocation of phenanthrene and pyrene in soils. Chemosphere 2004, 55, 1169–1178. [Google Scholar] [CrossRef]
- Shi, K.; Xue, J.; Xiao, X.; Qiao, Y.; Wu, Y.; Gao, Y. Mechanism of degrading petroleum hydrocarbons by compound marine petroleum-degrading bacteria: Surface adsorption, cell uptake, and biodegradation. Energy Fuels 2019, 33, 11373–11379. [Google Scholar] [CrossRef]
- Ramasamy, S.; Arumugam, A.; Chandran, P. Optimization of Enterobacter cloacae (KU923381) for diesel oil degradation using response surface methodology (RSM). J. Microbiol. 2017, 55, 104–111. [Google Scholar] [CrossRef]
- Ghazali, F.M.; Rahman, R.N.Z.A.; Salleh, A.B.; Basri, M. Biodegradation of hydrocarbons in soil by microbial consortium. Int. Biodeterior. Biodegrad. 2004, 54, 61–67. [Google Scholar] [CrossRef]
- Mulligan, C.N.; Yong, R.N.; Gibbs, B.F. Surfactant-enhanced remediation of contaminated soil: A review. Eng. Geol. 2001, 60, 371–380. [Google Scholar] [CrossRef]
- Haider, F.U.; Ejaz, M.; Cheema, S.A.; Khan, M.I.; Zhao, B.; Liqun, C.; Salim, M.A.; Naveed, M.; Khan, N.; Núñez-Delgado, A. Phytotoxicity of petroleum hydrocarbons: Sources, impacts and remediation strategies. Environ. Res. 2021, 111031. [Google Scholar] [CrossRef] [PubMed]
- Mehta, S.; Nautiyal, C.S. An efficient method for qualitative screening of phosphate-solubilizing bacteria. Curr. Microbiol. 2001, 43, 51–56. [Google Scholar] [CrossRef] [PubMed]
- Wang, X.; Wang, G.; Guo, T.; Xing, Y.; Mo, F.; Wang, H.; Fan, J.; Zhang, F. Effects of plastic mulch and nitrogen fertilizer on the soil microbial community, enzymatic activity and yield performance in a dryland maize cropping system. Eur. J. Soil Sci. 2021, 72, 400–412. [Google Scholar] [CrossRef]
- Wang, X.; Fan, J.; Xing, Y.; Xu, G.; Wang, H.; Deng, J.; Wang, Y.; Zhang, F.; Li, P.; Li, Z. The effects of mulch and nitrogen fertilizer on the soil environment of crop plants. Adv. Agron. 2019, 153, 121–173. [Google Scholar]

| Medium Name | Ingredients (g/L) | Persistence |
|---|---|---|
| Luria Bertani broth (LB) (Bertani, 2004) | NaCl 10; Tryptone 10; pH 7.0 yeast extract 5 | Cultivation of bacterial cultures |
| Nutrient broth/agar (NA) | Peptone 10; NaCl 5; yeast extract 3; pH 7.0 Agar 20 | Maintenance of bacterial cultures |
| Bushnell and Haas medium (BH) (Bushnell and Haas, 1941) | KH2PO4,1.0; K2HPO4, 1.0; NH4NO3, 1.0; MgSO4.7H2O, 0.2; FeCl3, 0.05; CaCl2.2H2O, 0.02; pH 7.0 Agar 20 | Preparation of inoculum, screening, and isolation of crude oil degraders |
| Phosphate solubilizing medium | Glucose 10, Ca3(PO4)2 2.5, MgCl2.6H2O 5, KCl 0.2, (NH4)2SO4 0.1, MgSO4 0.25, | Phosphate solubilizing |
| Factor 1 (Bacterial Isolates) | Factor 2 (Crude Oil Contamination) |
|---|---|
| No strain (S0) | Control (L0) 0 ppm |
| PMEL-63 (S1) | L2 1000 ppm |
| PMEL-67 (S2) | L4 2000 ppm |
| PMEL-80 (S3) | |
| PMEL-79 (S4) |
| Isolates | Bioremediation Assay | Exo-Polysaccharide Production | Phosphate Solubilization |
|---|---|---|---|
| N1 | + | ↑ | ↑ |
| L1 | ++ | ↑ | ↑ |
| M1 | _ | ↓ | ↓ |
| H1 | _ | ↓ | ↓ |
| H2 | +++ | ↑ | ↑ |
| N + O | _ | ↓ | ↓ |
| L + O | _ | ↓ | ↓ |
| M + O | ++ | ↑ | ↑ |
| H + O | _ | ↓ | ↓ |
| O1 | _ | ↓ | ↓ |
| Strains | F1 | F2 | F3 | F4 |
|---|---|---|---|---|
| S0 | −5.109 | −0.888 | −0.655 | 0.729 |
| S1 | −1.911 | 1.087 | −0.956 | −1.004 |
| S2 | 0.201 | 2.148 | 1.473 | 0.360 |
| S3 | 0.967 | −2.219 | 1.286 | −0.456 |
| S4 | 5.852 | −0.128 | −1.148 | 0.371 |
Publisher’s Note: MDPI stays neutral with regard to jurisdictional claims in published maps and institutional affiliations. |
© 2021 by the authors. Licensee MDPI, Basel, Switzerland. This article is an open access article distributed under the terms and conditions of the Creative Commons Attribution (CC BY) license (https://creativecommons.org/licenses/by/4.0/).
Share and Cite
Ejaz, M.; Zhao, B.; Wang, X.; Bashir, S.; Haider, F.U.; Aslam, Z.; Khan, M.I.; Shabaan, M.; Naveed, M.; Mustafa, A. Isolation and Characterization of Oil-Degrading Enterobacter sp. from Naturally Hydrocarbon-Contaminated Soils and Their Potential Use against the Bioremediation of Crude Oil. Appl. Sci. 2021, 11, 3504. https://doi.org/10.3390/app11083504
Ejaz M, Zhao B, Wang X, Bashir S, Haider FU, Aslam Z, Khan MI, Shabaan M, Naveed M, Mustafa A. Isolation and Characterization of Oil-Degrading Enterobacter sp. from Naturally Hydrocarbon-Contaminated Soils and Their Potential Use against the Bioremediation of Crude Oil. Applied Sciences. 2021; 11(8):3504. https://doi.org/10.3390/app11083504
Chicago/Turabian StyleEjaz, Mukkaram, Baowei Zhao, Xiukang Wang, Safdar Bashir, Fasih Ullah Haider, Zubair Aslam, Muhammad Imran Khan, Muhammad Shabaan, Muhammad Naveed, and Adnan Mustafa. 2021. "Isolation and Characterization of Oil-Degrading Enterobacter sp. from Naturally Hydrocarbon-Contaminated Soils and Their Potential Use against the Bioremediation of Crude Oil" Applied Sciences 11, no. 8: 3504. https://doi.org/10.3390/app11083504
APA StyleEjaz, M., Zhao, B., Wang, X., Bashir, S., Haider, F. U., Aslam, Z., Khan, M. I., Shabaan, M., Naveed, M., & Mustafa, A. (2021). Isolation and Characterization of Oil-Degrading Enterobacter sp. from Naturally Hydrocarbon-Contaminated Soils and Their Potential Use against the Bioremediation of Crude Oil. Applied Sciences, 11(8), 3504. https://doi.org/10.3390/app11083504

